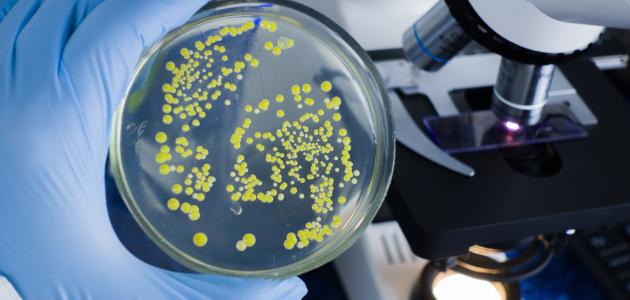

‘);
}
أهمية البكتيريا في الصناعة
تُعتبر البكتيريا (Bacteria) من الكائنات وحيدة الخلية التي تعيش في كلّ مكان على الأرض؛ فهي موجودة في التربة، والماء، وداخل الإنسان، والحيوان، والنبات، وكذلك في البراكين والمخلفات الإشعاعية، وهي قادرة على التأقلم جيدًا مع بيئتها،[١] وللبكتيريا أهمية كبيرة في العديد من المجالات، من أبرزها المجال الصناعي:
صناعة الأدوية
يَستخدم علم الأحياء الدقيقة الصناعي (Industrial microbiology) في أحد مجالاته كائنات حية معيّنة بما فيها البكتيريا لتصنيع المستحضرات الصيدلانية لأغراض طبية؛ فمثلًا هناك المضادات الحيوية التي يُستخدم التخمر في تصنيعها، والتي تعد ضرورية لعلاج العديد من الأمراض البكتيرية، إلى جانب ذلك، تُصنع أعداد كبيرة من الفيتامينات عن طريق التخمر أو التحوّل البيولوجي، فمثلًا، يتم إنتاج فيتامين B2 الذي يُطلق عليه الريبوفلافين إمّا عن طريق التحوّل البيولوجي بالاستعانة بالجلوكوز لإتمام العملية، ويُستخدم فطر أشبيا جوسيبي (Ashbya gossypii) كأساس في إنتاج هذا الفيتامين، أو عن طريق التخمير.
‘);
}
صناعة الأغذية
ومن ذلك ما يأتي:
- صناعة الألبان
يشيع استخدام البكتيريا في تصنيع مجموعة واسعة ومتنوّعة من المنتجات الغذائية، وتحديدًا منتجات الألبان، ومن أبرز أنواع البكتيريا المُستخدمة في هذا المجال هي بكتيريا اللاكتوباسيلس (Lactobacillus) التي يُطلق عليها أيضًا اسم بكتيريا اللاكتيك.[٢]
- صناعة المخبوزات
رغم أنّ الخميرة هي المسؤول الأساسي عن ارتفاع المخبوزات، إلّا أنّ لبكتيريا اللاكتيك دورًا مهمًا أيضًا؛ فهي بمثابة خميرة العجين الحامض (Sour dough) لإنتاج ما يُعرف بخبز العجينة المتخمرة، وتوجد هذه البكتيريا في الألبان، وتُسهّل تعامل الخبّاز مع العجينة، وتُقلل من حاجتها لفترة راحة طويلة، كما تمنحها رائحة جيدة وتُحافظ عليها طازجة لفترات أطول.
- صناعة المخللات
تُستخدم بكتيريا اللاكتيك أيضًا في تحضير المخللات أبرزها مخلل الملفوف.
- صناعة الكحول
تُستخدم الخمائر وأنواع أخرى من البكتيريا في صناعة الكحول، وأحد أبرز أنواعه وهو الإيثانول، والذي يُستخدم كمصدر وقود أحيانًا لتشغيل السيارات.
مكافحة الآفات
واحدة من تطبيقات الإدارة البيولوجية للآفات هي استخدام البكتيريا كبديل للمبيدات الحشرية، وتُعتبر البكتيريا الممرضة للحشرات (Bacillus thuringiensis) أو كما يُطلق عليها اختصارًا BT الأكثر شيوعًا في هذا المجال، وهي تتواجد في التربة، وتُستخدم للقضاء على حرشفيات الأجنحة (Lepidopteran) على وجه التحديد، ومن الجدير بالذكر أن استخدام البكتيريا لمكافحة الآفات هي واحدة من التقنيات الصديقة للبيئة؛ إذ إنّ تأثيرها في الإنسان، أو الحياة البرية، أو الحشرات الملقِحة وغيرها من الحشرات النافعة يُعتبر ضئيلًا.
الصناعات الهندسية
تُعتبر البكتيريا في الوقت الحاضر جزءًا من الأدوات الهندسية المستخدمة لتحسين التربة، ومنع التعرية، والحفر بما في ذلك حفر الأنفاق؛ وذلك يعود إلى قدرة العديد من أنواع البكتيريا على تعزيز ترسيب كربونات المعادن مثل كربونات الكالسيوم مثلًا كأحد نواتج عملية التمثيل الغذائي لديها -أي للبكتيريا، ومن جهةٍ أخرى، أشارت المختبرات وكذلك التجارب الميدانية إلى فائدة التمعدن الحيوي في مواد البناء، إلّا أنّ هناك العديد من التحديات أمام ذلك؛ فمثلًا، يتم في الوقت الحالي البحث عن طرق لتحسين بقاء البكتيريا داخل الباطون أو الخرسانة.[٣]
المراجع
- ↑“Bacteria in food production”, EFFCA: European Food & Feed Cultures Association, Retrieved 12/1/2022. Edited.
- ↑“Bacteria in Industry”, vedantu, Retrieved 12/1/2022. Edited.
- ↑“BACTERIA IN INDUSTRY”, microbiologysociety, Retrieved 12/1/2022. Edited.



